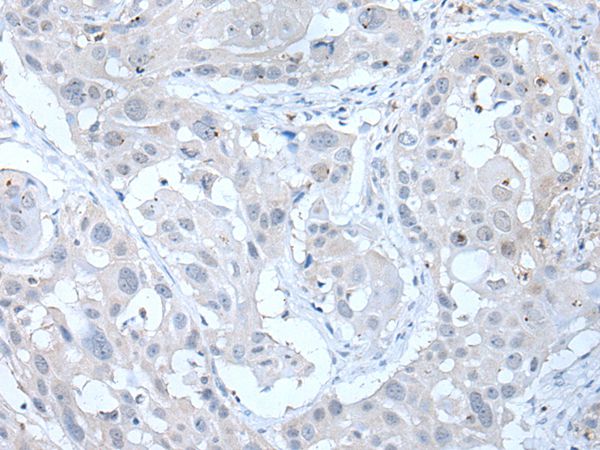

Western blot analysis using anti-ANGPTL6 (human), pAb (Prod. No. AG-25A-0037) at 1:2000 dilution. 1: Human ANGPTL6 (FLAG®-tagged). 2: HepG2 cell lysate.
anti-ANGPTL6 (human), pAb
AG-25A-0037
ApplicationsWestern Blot, ELISA
Product group Antibodies
ReactivityHuman
TargetANGPTL6
Overview
- SupplierAdipoGen Life Sciences
- Product Nameanti-ANGPTL6 (human), pAb
- Delivery Days Customer10
- ApplicationsWestern Blot, ELISA
- CertificationResearch Use Only
- ClonalityPolyclonal
- Concentration1 mg/ml
- Gene ID83854
- Target nameANGPTL6
- Target descriptionangiopoietin like 6
- Target synonymsAGF, ARP5, angiopoietin-related protein 6, angiopoietin-like protein 6, angiopoietin-related growth factor, angiopoietin-related protein 5
- HostRabbit
- Protein IDQ8NI99
- Protein NameAngiopoietin-related protein 6
- Scientific DescriptionANGPTL6 regulates angiogenesis and also directly regulates lipid, glucose, and energy metabolism. The serum levels of ANGPTL6 are significantly increased in obese humans, patients with type 2 diabetes mellitus (T2DM), and in metabolic syndrome. - Polyclonal Antibody. Recognizes human ANGPTL6. Detects a band of ~52kDa by Western blot. Source: Rabbit. Applications: ELISA, WB. Liquid. 0.2microm-filtered solution in PBS, pH 7.4. Contains no preservatives. ANGPTL6 regulates angiogenesis and also directly regulates lipid, glucose, and energy metabolism. The serum levels of ANGPTL6 are significantly increased in obese humans, patients with type 2 diabetes mellitus (T2DM), and in metabolic syndrome.
- ReactivityHuman
- Storage Instruction-20°C,2°C to 8°C
- UNSPSC12352203